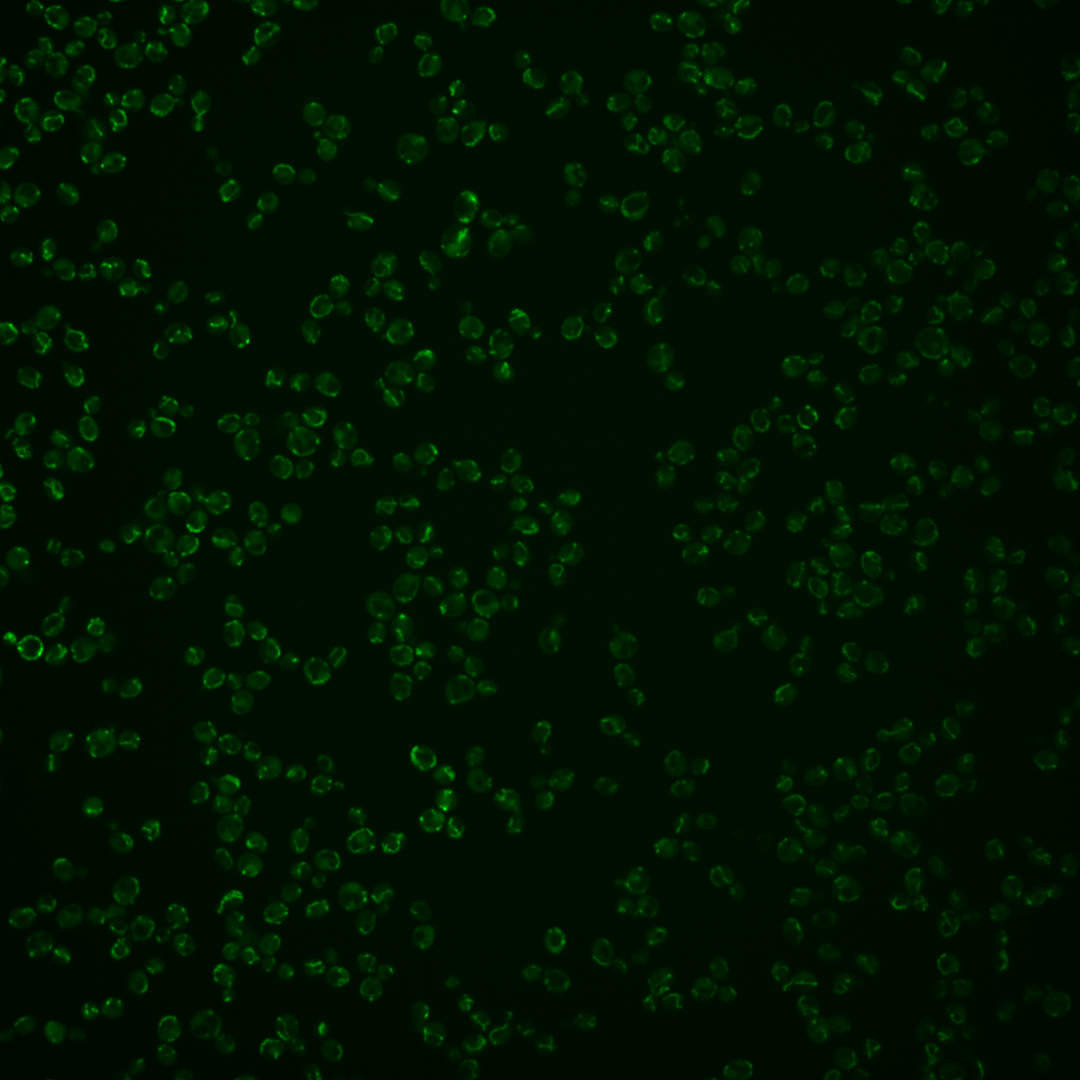

| Standard name | |
|---|---|
| Human Ortholog | |
| Description | Subunit 2 of ubiquinol cytochrome-c reductase (Complex III); Complex III is a component of the mitochondrial inner membrane electron transport chain; phosphorylated; transcription is regulated by Hap1p, Hap2p/Hap3p, and heme |
Micrographs




















































































Sub-cellular Localization
Yeast GFP Assignment
Protein Abundance
Localization Change
External localization resources
| ensLOC | DeepLoc | |||||||||||||||||||||||
|---|---|---|---|---|---|---|---|---|---|---|---|---|---|---|---|---|---|---|---|---|---|---|---|---|
| Localization | WT1 | WT2 | WT3 | RAP60 | RAP140 | RAP220 | RAP300 | RAP380 | RAP460 | RAP540 | RAP620 | RAP700 | HU80 | HU120 | HU160 | rpd3Δ_1 | rpd3Δ_2 | rpd3Δ_3 | WT1 | WT2 | WT3 | AF100 | AF140 | AF180 |
| Cortical Patches | 0 | 0 | 2 | 0 | 0 | 3 | 2 | 4 | – | 0 | 0 | 1 | 7 | 2 | 1 | 8 | 3 | 3 | 6 | 9 | 4 | 18 | 35 | 32 |
| Bud | 1 | 0 | 9 | 13 | 20 | 26 | 18 | 20 | – | 13 | 18 | 9 | 4 | 7 | 2 | 5 | 4 | 10 | 0 | 0 | 0 | 1 | 1 | 5 |
| Bud Neck | 0 | 0 | 0 | 0 | 0 | 0 | 0 | 0 | – | 0 | 0 | 0 | 0 | 0 | 0 | 0 | 0 | 0 | 0 | 0 | 0 | 0 | 0 | 1 |
| Bud Site | 0 | 0 | 4 | 0 | 0 | 8 | 3 | 7 | – | 10 | 5 | 3 | 0 | 0 | 0 | 1 | 0 | 0 | – | – | – | – | – | – |
| Cell Periphery | 2 | 6 | 4 | 5 | 6 | 2 | 5 | 3 | – | 7 | 3 | 1 | 6 | 9 | 6 | 10 | 2 | 3 | 0 | 0 | 0 | 0 | 0 | 0 |
| Cytoplasm | 1 | 1 | 0 | 8 | 15 | 14 | 12 | 14 | – | 10 | 6 | 6 | 1 | 2 | 5 | 7 | 8 | 7 | 0 | 0 | 0 | 1 | 0 | 4 |
| Endoplasmic Reticulum | 4 | 3 | 3 | 1 | 1 | 4 | 1 | 3 | – | 1 | 1 | 1 | 1 | 0 | 0 | 3 | 4 | 2 | 0 | 0 | 0 | 2 | 2 | 3 |
| Endosome | 5 | 0 | 10 | 2 | 27 | 5 | 5 | 5 | – | 2 | 2 | 2 | 4 | 19 | 14 | 11 | 6 | 6 | 11 | 4 | 12 | 9 | 10 | 15 |
| Golgi | 7 | 1 | 3 | 0 | 2 | 0 | 0 | 1 | – | 0 | 1 | 4 | 40 | 32 | 71 | 20 | 12 | 16 | 21 | 19 | 21 | 28 | 40 | 42 |
| Mitochondria | 219 | 135 | 346 | 217 | 424 | 598 | 869 | 782 | – | 741 | 673 | 459 | 176 | 300 | 167 | 10 | 5 | 10 | 177 | 101 | 240 | 166 | 178 | 175 |
| Nucleus | 2 | 0 | 0 | 0 | 0 | 4 | 4 | 4 | – | 4 | 0 | 2 | 0 | 1 | 2 | 2 | 1 | 0 | 0 | 0 | 0 | 0 | 0 | 0 |
| Nuclear Periphery | 18 | 8 | 17 | 4 | 26 | 50 | 87 | 42 | – | 52 | 39 | 19 | 4 | 5 | 3 | 4 | 5 | 1 | 3 | 0 | 1 | 1 | 5 | 4 |
| Nucleolus | 11 | 8 | 14 | 4 | 31 | 64 | 164 | 180 | – | 91 | 86 | 55 | 2 | 7 | 3 | 4 | 6 | 6 | 0 | 0 | 0 | 0 | 1 | 3 |
| Peroxisomes | 12 | 1 | 40 | 22 | 31 | 16 | 13 | 29 | – | 25 | 6 | 4 | 13 | 48 | 9 | 44 | 25 | 36 | 29 | 10 | 63 | 55 | 46 | 30 |
| SpindlePole | 1 | 1 | 7 | 0 | 9 | 5 | 5 | 7 | – | 12 | 6 | 3 | 1 | 6 | 0 | 7 | 3 | 2 | 1 | 0 | 1 | 2 | 0 | 1 |
| Vac/Vac Membrane | 18 | 12 | 8 | 0 | 35 | 17 | 23 | 21 | – | 28 | 16 | 21 | 24 | 32 | 34 | 14 | 9 | 12 | 6 | 2 | 0 | 3 | 3 | 8 |
| Unique Cell Count | 244 | 146 | 359 | 231 | 500 | 670 | 993 | 940 | 834 | 709 | 499 | 203 | 351 | 227 | 121 | 76 | 94 | 259 | 153 | 350 | 295 | 329 | 333 | |
| Labelled Cell Count | 301 | 176 | 467 | 276 | 627 | 816 | 1211 | 1122 | 996 | 862 | 590 | 283 | 470 | 317 | 150 | 93 | 114 | 259 | 153 | 350 | 295 | 329 | 333 | |
Yeast GFP Assignment
Protein Abundance
| Screen | WT1 | WT2 | WT3 | RAP60 | RAP140 | RAP220 | RAP300 | RAP380 | RAP460 | RAP540 | RAP620 | RAP700 | HU80 | HU120 | HU160 | rpd3Δ_1 | rpd3Δ_2 | rpd3Δ_3 | AF100 | AF140 | AF180 |
|---|---|---|---|---|---|---|---|---|---|---|---|---|---|---|---|---|---|---|---|---|---|
| Mean Cell GFP Intensity (1e-4) | 10.4 | 8.9 | 6.6 | 7.1 | 8.0 | 9.3 | 9.8 | 11.5 | – | 13.0 | 14.6 | 15.3 | 10.6 | 10.6 | 10.4 | 10.2 | 9.7 | 10.5 | 13.6 | 15.8 | 17.3 |
| Std Deviation (1e-4) | 3.0 | 2.1 | 1.7 | 1.8 | 1.9 | 2.1 | 2.7 | 3.4 | – | 5.2 | 5.9 | 6.8 | 2.2 | 4.0 | 2.7 | 3.6 | 2.9 | 4.1 | 9.7 | 13.6 | 13.9 |
| Intensity Change (Log2) | – | – | – | 0.1 | 0.28 | 0.49 | 0.56 | 0.8 | – | 0.97 | 1.14 | 1.21 | 0.68 | 0.68 | 0.65 | 0.62 | 0.55 | 0.67 | 1.03 | 1.25 | 1.39 |
Localization Change
| Localization | RAP60 | RAP140 | RAP220 | RAP300 | RAP380 | RAP460 | RAP540 | RAP620 | RAP700 | HU80 | HU120 | HU160 | rpd3Δ_1 | rpd3Δ_2 | rpd3Δ_3 |
|---|---|---|---|---|---|---|---|---|---|---|---|---|---|---|---|
| Cortical Patches | 0 | 0 | 0 | 0 | 0 | – | 0 | 0 | 0 | 0 | 0 | 0 | 0 | 0 | 0 |
| Bud | 2.0 | 1.2 | 1.2 | -0.8 | -0.4 | – | -1.1 | 0 | -0.7 | 0 | -0.5 | 0 | 0 | 0 | 0 |
| Bud Neck | 0 | 0 | 0 | 0 | 0 | – | 0 | 0 | 0 | 0 | 0 | 0 | 0 | 0 | 0 |
| Bud Site | 0 | 0 | 0 | 0 | 0 | – | 0 | 0 | 0 | 0 | 0 | 0 | 0 | 0 | 0 |
| Cell Periphery | 0 | 0 | 0 | 0 | 0 | – | 0 | 0 | 0 | 0 | 1.4 | 0 | 0 | 0 | 0 |
| Cytoplasm | 0 | 3.3 | 0 | 0 | 0 | – | 0 | 0 | 0 | 0 | 0 | 0 | 0 | 0 | 0 |
| Endoplasmic Reticulum | 0 | 0 | 0 | 0 | 0 | – | 0 | 0 | 0 | 0 | 0 | 0 | 0 | 0 | 0 |
| Endosome | 0 | 1.9 | -2.6 | 0 | 0 | – | 0 | 0 | -2.9 | -0.6 | 1.8 | 2.0 | 2.9 | 0 | 0 |
| Golgi | 0 | 0 | 0 | 0 | 0 | – | 0 | 0 | 0 | 8.1 | 5.1 | 10.8 | 7.0 | 0 | 0 |
| Mitochondria | -1.4 | -5.5 | -4.0 | -4.8 | -6.3 | – | -4.2 | -1.1 | -2.6 | -4.3 | -5.1 | -8.1 | -19.2 | -18.0 | -18.0 |
| Nucleus | 0 | 0 | 0 | 0 | 0 | – | 0 | 0 | 0 | 0 | 0 | 0 | 0 | 0 | 0 |
| Nuclear Periphery | -1.9 | 0.3 | 1.7 | 2.5 | -0.2 | – | 1.0 | 0.5 | -0.7 | -1.7 | -2.5 | -2.2 | -0.7 | 0 | 0 |
| Nucleolus | -1.5 | 1.5 | 3.3 | 6.1 | 6.9 | – | 3.9 | 4.4 | 3.8 | -2.0 | -1.5 | -1.8 | 0 | 0 | 0 |
| Peroxisomes | -0.6 | -2.6 | -5.9 | -8.2 | -5.8 | – | -5.7 | -7.8 | -6.8 | -1.8 | 1.0 | -3.1 | 6.3 | 4.8 | 6.3 |
| SpindlePole | 0 | -0.2 | 0 | 0 | 0 | – | -0.6 | 0 | 0 | 0 | -0.2 | 0 | 0 | 0 | 0 |
| Vacuole | 0 | 3.2 | 0.3 | 0.1 | 0 | – | 1.0 | 0 | 1.6 | 4.7 | 4.0 | 5.8 | 4.2 | 0 | 0 |
External localization resources
Images






























Protein Concentration and Protein Localization Data
| R1 | R2 | R3 | ||||||||||||||||
|---|---|---|---|---|---|---|---|---|---|---|---|---|---|---|---|---|---|---|
| G1 Pre-START | G1 Post-START | S/G2 | Metaphase | Anaphase | Telophase | G1 Pre-START | G1 Post-START | S/G2 | Metaphase | Anaphase | Telophase | G1 Pre-START | G1 Post-START | S/G2 | Metaphase | Anaphase | Telophase | |
| Concentration | 17.0633 | 21.3716 | 19.4856 | 18.6228 | 18.1012 | 20.0735 | 22.6143 | 26.2378 | 24.1486 | 24.7 | 20.3343 | 24.51 | 24.5017 | 25.5831 | 24.6167 | 25.2521 | 24.9459 | 26.024 |
| Actin | 0.0241 | 0.0221 | 0.0129 | 0.004 | 0.0047 | 0.0078 | 0.0147 | 0.0023 | 0.0269 | 0.0354 | 0.0037 | 0.0045 | 0.0123 | 0.0086 | 0.0041 | 0.0136 | 0.0081 | 0.0009 |
| Bud | 0.0001 | 0.0001 | 0 | 0 | 0 | 0 | 0.0004 | 0 | 0.0001 | 0.0006 | 0 | 0.0001 | 0 | 0.0001 | 0 | 0.0001 | 0 | 0 |
| Bud Neck | 0.0001 | 0.0001 | 0 | 0 | 0 | 0 | 0.0005 | 0 | 0 | 0 | 0 | 0.0005 | 0.0001 | 0 | 0 | 0.0009 | 0 | 0 |
| Bud Periphery | 0.0003 | 0.0002 | 0 | 0 | 0.0001 | 0 | 0.0008 | 0 | 0.0001 | 0.0007 | 0.0001 | 0.0001 | 0 | 0.0001 | 0 | 0.0005 | 0 | 0 |
| Bud Site | 0.0004 | 0.0003 | 0 | 0.0001 | 0.0001 | 0 | 0.0019 | 0 | 0.0004 | 0.0012 | 0.0001 | 0.0004 | 0.0001 | 0.0001 | 0.0001 | 0.0001 | 0 | 0 |
| Cell Periphery | 0.0002 | 0.0002 | 0.0001 | 0.0001 | 0.0001 | 0.0001 | 0.0003 | 0.0001 | 0 | 0.0001 | 0 | 0.0001 | 0.0001 | 0.0002 | 0.0001 | 0.0001 | 0 | 0 |
| Cytoplasm | 0 | 0 | 0 | 0 | 0 | 0 | 0.0006 | 0 | 0.0001 | 0 | 0 | 0 | 0.0001 | 0 | 0 | 0.0003 | 0 | 0 |
| Cytoplasmic Foci | 0.0041 | 0.0023 | 0.0007 | 0.0016 | 0.0028 | 0.0007 | 0.0044 | 0.0006 | 0.0024 | 0.0003 | 0.0005 | 0.0013 | 0.0008 | 0.0007 | 0.0024 | 0.0002 | 0.0001 | 0.0002 |
| Eisosomes | 0.0016 | 0.0017 | 0.0009 | 0.0005 | 0.0005 | 0.001 | 0.0011 | 0.0003 | 0.0012 | 0.0004 | 0.0005 | 0.0005 | 0.0008 | 0.0004 | 0.0007 | 0.0012 | 0.0005 | 0.0003 |
| Endoplasmic Reticulum | 0.0001 | 0 | 0 | 0 | 0.0001 | 0 | 0.0003 | 0 | 0.0002 | 0 | 0 | 0 | 0.0001 | 0 | 0 | 0.0023 | 0 | 0 |
| Endosome | 0.0038 | 0.0036 | 0.0017 | 0.0021 | 0.0085 | 0.0019 | 0.0037 | 0.0009 | 0.0074 | 0.001 | 0.0007 | 0.0013 | 0.0008 | 0.0015 | 0.0008 | 0.0033 | 0.0005 | 0.0003 |
| Golgi | 0.0505 | 0.0336 | 0.0156 | 0.0084 | 0.0314 | 0.0233 | 0.0044 | 0.0073 | 0.0074 | 0.0359 | 0.0036 | 0.0158 | 0.0048 | 0.0228 | 0.0087 | 0.0043 | 0.0064 | 0.0015 |
| Lipid Particles | 0.0352 | 0.0261 | 0.0117 | 0.0119 | 0.0417 | 0.0096 | 0.034 | 0.0078 | 0.0164 | 0.0012 | 0.0238 | 0.0168 | 0.0213 | 0.0119 | 0.0122 | 0.0022 | 0.004 | 0.0055 |
| Mitochondria | 0.8323 | 0.8849 | 0.9367 | 0.9559 | 0.8971 | 0.9416 | 0.8757 | 0.9696 | 0.9138 | 0.9185 | 0.9551 | 0.944 | 0.9397 | 0.9349 | 0.9564 | 0.945 | 0.9642 | 0.9853 |
| None | 0.0001 | 0 | 0 | 0 | 0 | 0 | 0.016 | 0 | 0.0002 | 0 | 0 | 0 | 0.0002 | 0 | 0.0001 | 0.0011 | 0 | 0 |
| Nuclear Periphery | 0.0005 | 0.0001 | 0 | 0.0001 | 0.0001 | 0 | 0.0009 | 0 | 0.0011 | 0 | 0 | 0.0001 | 0.0001 | 0.0001 | 0 | 0.0071 | 0 | 0.0001 |
| Nucleolus | 0.0005 | 0.0002 | 0.0001 | 0.0002 | 0.0001 | 0 | 0.0009 | 0.0001 | 0.0001 | 0 | 0.0001 | 0.0001 | 0.0002 | 0.0003 | 0.0004 | 0.0003 | 0 | 0 |
| Nucleus | 0.0002 | 0 | 0 | 0 | 0 | 0 | 0.0003 | 0 | 0.0001 | 0 | 0 | 0 | 0.0001 | 0.0002 | 0.0001 | 0.0016 | 0 | 0 |
| Peroxisomes | 0.0383 | 0.0162 | 0.0135 | 0.0106 | 0.0099 | 0.0105 | 0.0254 | 0.0086 | 0.0195 | 0.0038 | 0.0112 | 0.0102 | 0.0097 | 0.0071 | 0.0105 | 0.0012 | 0.0032 | 0.0029 |
| Punctate Nuclear | 0 | 0 | 0 | 0 | 0 | 0 | 0.0004 | 0 | 0.0007 | 0 | 0 | 0 | 0.0001 | 0 | 0.0002 | 0.0005 | 0 | 0 |
| Vacuole | 0.0031 | 0.0009 | 0.0004 | 0.0003 | 0.0005 | 0.0003 | 0.002 | 0.0003 | 0.0005 | 0.0001 | 0.0001 | 0.0003 | 0.0006 | 0.0022 | 0.0003 | 0.0017 | 0.0002 | 0.0002 |
| Vacuole Periphery | 0.0045 | 0.0072 | 0.0055 | 0.004 | 0.0022 | 0.0029 | 0.0114 | 0.0021 | 0.0011 | 0.0007 | 0.0005 | 0.0038 | 0.008 | 0.0087 | 0.0028 | 0.0125 | 0.0126 | 0.0027 |
Sequencing Data
| R1 | R2 | |||||||||
|---|---|---|---|---|---|---|---|---|---|---|
| G1 Post-START | S/G2 | Metaphase | Anaphase | Telophase | G1 Post-START | S/G2 | Metaphase | Anaphase | Telophase | |
| Gene Expression | 53.3262 | 51.6801 | 60.168 | 80.9974 | 62.6781 | 53.7948 | 48.8752 | 54.7257 | 64.2744 | 55.059 |
| Translational Efficiency | 1.291 | 1.2675 | 1.5706 | 1.5024 | 1.6627 | 1.5227 | 1.536 | 1.6913 | 1.648 | 1.5076 |
Hit Data
| Dataset | Hit |
|---|---|
| Protein Concentration | ✘ |
| Protein Localization | ✘ |
| Gene Expression | ✘ |
| Translational Efficiency | ✘ |
Micrographs
































Cell Count
| R1 | R2 | R1 & R2 | |||||||||
|---|---|---|---|---|---|---|---|---|---|---|---|
| WT | UBP2 | UBP14 | UBP2UBP14 | WT | UBP2 | UBP14 | UBP2UBP14 | WT | UBP2 | UBP14 | UBP2UBP14 |
| 1237 | 2032 | 1121 | 1034 | 1551 | 1482 | 1096 | 1752 | 2788 | 3514 | 2217 | 2786 |
Protein Abundance
| R1 | R2 | R1 & R2 | ||||||||||
|---|---|---|---|---|---|---|---|---|---|---|---|---|
| WT | UBP2 | UBP14 | UBP2UBP14 | WT | UBP2 | UBP14 | UBP2UBP14 | WT | UBP2 | UBP14 | UBP2UBP14 | |
| Mean | 823.51 | 1137.33 | 1611.50 | 2010.07 | 922.53 | 1092.97 | 1513.83 | 2090.07 | 878.60 | 1118.62 | 1563.22 | 2060.38 |
| Standard Deviation | 149.89 | 228.71 | 333.93 | 554.90 | 163.55 | 242.15 | 295.49 | 577.97 | 165.13 | 235.49 | 319.27 | 570.83 |
| Intensity Change Log 2 | — | 0.465793 | 0.968546 | 1.287388 | — | 0.244586 | 0.714535 | 1.179884 | — | 0.353151 | 0.839922 | 1.231587 |
Localization Score (DeepLoc)
| R1 | R2 | R1 & R2 | ||||||||||
|---|---|---|---|---|---|---|---|---|---|---|---|---|
| WT | UBP2 | UBP14 | UBP2UBP14 | WT | UBP2 | UBP14 | UBP2UBP14 | WT | UBP2 | UBP14 | UBP2UBP14 | |
| Actin | 0.002111 | 0.010540 | 0.005433 | 0.009406 | 0.016201 | 0.011801 | 0.002770 | 0.004831 | 0.009949 | 0.011072 | 0.004116 | 0.006529 |
| Bud Neck | 0.002228 | 0.000933 | 0.002136 | 0.001811 | 0.001798 | 0.001578 | 0.001520 | 0.000958 | 0.001989 | 0.001205 | 0.001831 | 0.001274 |
| Bud Site | 0.002796 | 0.002471 | 0.001328 | 0.003036 | 0.001855 | 0.001751 | 0.001532 | 0.001337 | 0.002273 | 0.002167 | 0.001429 | 0.001968 |
| Cell Periphery | 0.000326 | 0.000155 | 0.000088 | 0.000356 | 0.000283 | 0.000145 | 0.000052 | 0.000283 | 0.000302 | 0.000151 | 0.000070 | 0.000310 |
| Cytoplasm | 0.000506 | 0.001098 | 0.000260 | 0.000375 | 0.000581 | 0.000585 | 0.000302 | 0.000341 | 0.000548 | 0.000881 | 0.000281 | 0.000353 |
| Cytoplasmic Foci | 0.011755 | 0.026221 | 0.029563 | 0.010849 | 0.014110 | 0.021588 | 0.013191 | 0.006274 | 0.013065 | 0.024267 | 0.021469 | 0.007972 |
| Eisosomes | 0.000062 | 0.000537 | 0.000640 | 0.000862 | 0.000593 | 0.000830 | 0.000234 | 0.000707 | 0.000357 | 0.000660 | 0.000439 | 0.000765 |
| Endoplasmic Reticulum | 0.000214 | 0.000179 | 0.000255 | 0.000611 | 0.000231 | 0.000169 | 0.000074 | 0.000119 | 0.000223 | 0.000175 | 0.000165 | 0.000302 |
| Endosome | 0.022818 | 0.013112 | 0.004306 | 0.003490 | 0.015714 | 0.008586 | 0.003778 | 0.001706 | 0.018866 | 0.011203 | 0.004045 | 0.002368 |
| Golgi | 0.021415 | 0.071007 | 0.045327 | 0.036165 | 0.038357 | 0.049853 | 0.021208 | 0.019706 | 0.030840 | 0.062086 | 0.033403 | 0.025815 |
| Lipid Particles | 0.005689 | 0.016991 | 0.008847 | 0.005501 | 0.017919 | 0.014359 | 0.002717 | 0.001663 | 0.012493 | 0.015881 | 0.005817 | 0.003087 |
| Mitochondria | 0.897029* | 0.822396* | 0.858566* | 0.889309* | 0.836532* | 0.841628* | 0.926352* | 0.941446* | 0.863374* | 0.830507* | 0.892077* | 0.922096* |
| Mitotic Spindle | 0.001044 | 0.001849 | 0.002342 | 0.004939 | 0.000626 | 0.001774 | 0.003960 | 0.000819 | 0.000811 | 0.001817 | 0.003142 | 0.002348 |
| None | 0.000273 | 0.000688 | 0.004232 | 0.003097 | 0.000543 | 0.000829 | 0.001036 | 0.001960 | 0.000423 | 0.000748 | 0.002652 | 0.002382 |
| Nuclear Periphery | 0.000072 | 0.000149 | 0.001222 | 0.000609 | 0.000155 | 0.000148 | 0.000587 | 0.000168 | 0.000119 | 0.000149 | 0.000908 | 0.000331 |
| Nuclear Periphery Foci | 0.000143 | 0.000162 | 0.000585 | 0.000224 | 0.000215 | 0.000202 | 0.000309 | 0.000092 | 0.000183 | 0.000179 | 0.000448 | 0.000141 |
| Nucleolus | 0.000169 | 0.000162 | 0.000651 | 0.000459 | 0.000176 | 0.000560 | 0.000258 | 0.000317 | 0.000173 | 0.000330 | 0.000456 | 0.000370 |
| Nucleus | 0.000134 | 0.000075 | 0.000083 | 0.000085 | 0.000083 | 0.000190 | 0.000069 | 0.000065 | 0.000106 | 0.000124 | 0.000076 | 0.000073 |
| Peroxisomes | 0.025481 | 0.027318 | 0.009926 | 0.005866 | 0.051596 | 0.037425 | 0.009995 | 0.005779 | 0.040009 | 0.031580 | 0.009960 | 0.005812 |
| Vacuole | 0.002122 | 0.001747 | 0.006376 | 0.006762 | 0.001241 | 0.003606 | 0.004129 | 0.004274 | 0.001632 | 0.002531 | 0.005265 | 0.005197 |
| Vacuole Periphery | 0.003615 | 0.002211 | 0.017835 | 0.016188 | 0.001190 | 0.002394 | 0.005927 | 0.007154 | 0.002266 | 0.002288 | 0.011948 | 0.010507 |
Localization Changes (T-score)
| R1 | R2 | R1 & R2 | |||||||||||||
|---|---|---|---|---|---|---|---|---|---|---|---|---|---|---|---|
| UBP2_WT | UBP14_WT | UBP2UBP14_WT | UBP2UBP14_UBP2 | UBP2UBP14_UBP14 | UBP2_WT | UBP14_WT | UBP2UBP14_WT | UBP2UBP14_UBP2 | UBP2UBP14_UBP14 | UBP2_WT | UBP14_WT | UBP2UBP14_WT | UBP2UBP14_UBP2 | UBP2UBP14_UBP14 | |
| Actin | -8.85 | -3.47 | -4.60 | 0.61 | -2.20 | 2.09 | 6.99 | 5.74 | 5.06 | -1.94 | -0.91 | 5.00 | 2.65 | 4.31 | -2.51 |
| Bud Neck | 1.55 | 0.09 | 0.46 | -3.42 | 0.83 | 0.52 | 0.62 | 2.02 | 1.89 | 1.69 | 1.82 | 0.32 | 1.57 | -0.38 | 2.16 |
| Bud Site | 0.37 | 1.94 | -0.25 | -0.59 | -1.88 | 0.17 | 0.52 | 0.92 | 0.74 | 0.37 | 0.19 | 1.80 | 0.53 | 0.37 | -1.14 |
| Cell Periphery | 3.13 | 5.18 | -0.26 | -1.64 | -2.24 | 3.03 | 5.67 | -0.02 | -1.74 | -3.00 | 4.19 | 7.60 | -0.14 | -2.34 | -3.65 |
| Cytoplasm | -1.85 | 2.02 | 0.92 | 2.35 | -1.62 | -0.03 | 1.93 | 1.48 | 2.06 | -0.38 | -1.69 | 2.78 | 1.74 | 2.83 | -1.12 |
| Cytoplasmic Foci | -8.19 | -6.76 | 0.58 | 8.78 | 7.14 | -4.55 | 0.52 | 5.92 | 9.80 | 4.19 | -9.19 | -5.29 | 5.05 | 13.84 | 8.67 |
| Eisosomes | -13.35 | -10.47 | -7.49 | -2.89 | -1.85 | -2.63 | 6.06 | -0.95 | 0.96 | -4.39 | -6.31 | -1.88 | -4.86 | -1.22 | -3.92 |
| Endoplasmic Reticulum | 0.98 | -0.90 | -1.66 | -1.80 | -1.48 | 1.62 | 4.46 | 3.00 | 2.19 | -2.68 | 1.76 | 1.99 | -0.86 | -1.40 | -1.50 |
| Endosome | 4.03 | 8.30 | 8.64 | 7.74 | 0.95 | 4.29 | 7.64 | 9.34 | 8.34 | 3.48 | 5.31 | 11.23 | 12.76 | 11.57 | 3.42 |
| Golgi | -13.05 | -6.42 | -3.84 | 7.43 | 1.98 | -2.93 | 4.97 | 5.82 | 8.60 | 0.50 | -11.05 | -0.98 | 2.09 | 12.68 | 2.88 |
| Lipid Particles | -6.20 | -2.27 | 0.13 | 6.37 | 2.45 | 1.36 | 7.66 | 8.23 | 7.15 | 2.06 | -2.07 | 5.19 | 7.47 | 10.54 | 4.11 |
| Mitochondria | 8.50 | 4.08 | 0.85 | -7.11 | -3.05 | -0.53 | -10.23 | -13.34 | -12.90 | -2.30 | 4.99 | -4.36 | -9.87 | -15.75 | -5.19 |
| Mitotic Spindle | -1.81 | -2.74 | -2.61 | -2.01 | -1.69 | -1.99 | -3.51 | -0.85 | 1.63 | 3.29 | -2.84 | -4.40 | -2.68 | -0.84 | 1.05 |
| None | -7.85 | -11.98 | -15.00 | -12.43 | 2.99 | -3.95 | -7.60 | -14.55 | -10.44 | -8.94 | -7.22 | -12.83 | -21.07 | -16.69 | 1.39 |
| Nuclear Periphery | -3.64 | -6.10 | -6.48 | -5.46 | 2.99 | 0.09 | -2.67 | -0.15 | -0.65 | 2.94 | -0.66 | -6.26 | -3.82 | -5.00 | 4.69 |
| Nuclear Periphery Foci | -0.60 | -4.23 | -2.30 | -1.77 | 3.40 | 0.20 | -1.06 | 2.17 | 2.84 | 2.90 | 0.11 | -3.79 | 1.18 | 1.49 | 4.73 |
| Nucleolus | 0.19 | -2.30 | -2.75 | -3.21 | 0.88 | -1.86 | -1.14 | -1.56 | 1.17 | -0.75 | -1.57 | -2.55 | -2.86 | -0.41 | 0.76 |
| Nucleus | 1.41 | 1.38 | 1.28 | -0.38 | -0.15 | -0.95 | 0.34 | 0.46 | 1.13 | 0.11 | -0.34 | 1.09 | 1.18 | 1.01 | 0.14 |
| Peroxisomes | -0.52 | 4.99 | 6.52 | 9.28 | 2.12 | 3.06 | 10.60 | 12.40 | 10.13 | 2.22 | 2.93 | 11.61 | 13.89 | 13.89 | 3.10 |
| Vacuole | 0.94 | -6.04 | -3.85 | -4.20 | -0.35 | -3.21 | -4.84 | -3.76 | -0.64 | -0.15 | -2.39 | -7.90 | -5.26 | -3.65 | 0.05 |
| Vacuole Periphery | 2.55 | -8.67 | -6.80 | -7.69 | 0.68 | -3.02 | -7.27 | -8.66 | -6.09 | -1.31 | -0.08 | -10.85 | -10.02 | -9.90 | 1.22 |
Endocytosis
| Temp | Actin Patch (Sac6-tdTomato) | Cortical Patch (Sla1-GFP) | Late Endosome (Snf7-GFP) | Vacuole (Vph1-GFP) |
|---|---|---|---|---|
| 37℃ | ||||
| RT |
Cell Cycle Omics
CYCLoPs (Qcr2-GFP)
| Gene / Allele | Actin Patch (Sac6-tdTomato) | Cortical Patch (Sla1-GFP) | Late Endosome (Snf7-GFP) | Vacuole (Sac6-tdTomato) |
|---|
| Gene | Images |
|---|
| Gene | Images |
|---|
Images are not yet available
Images are not yet available